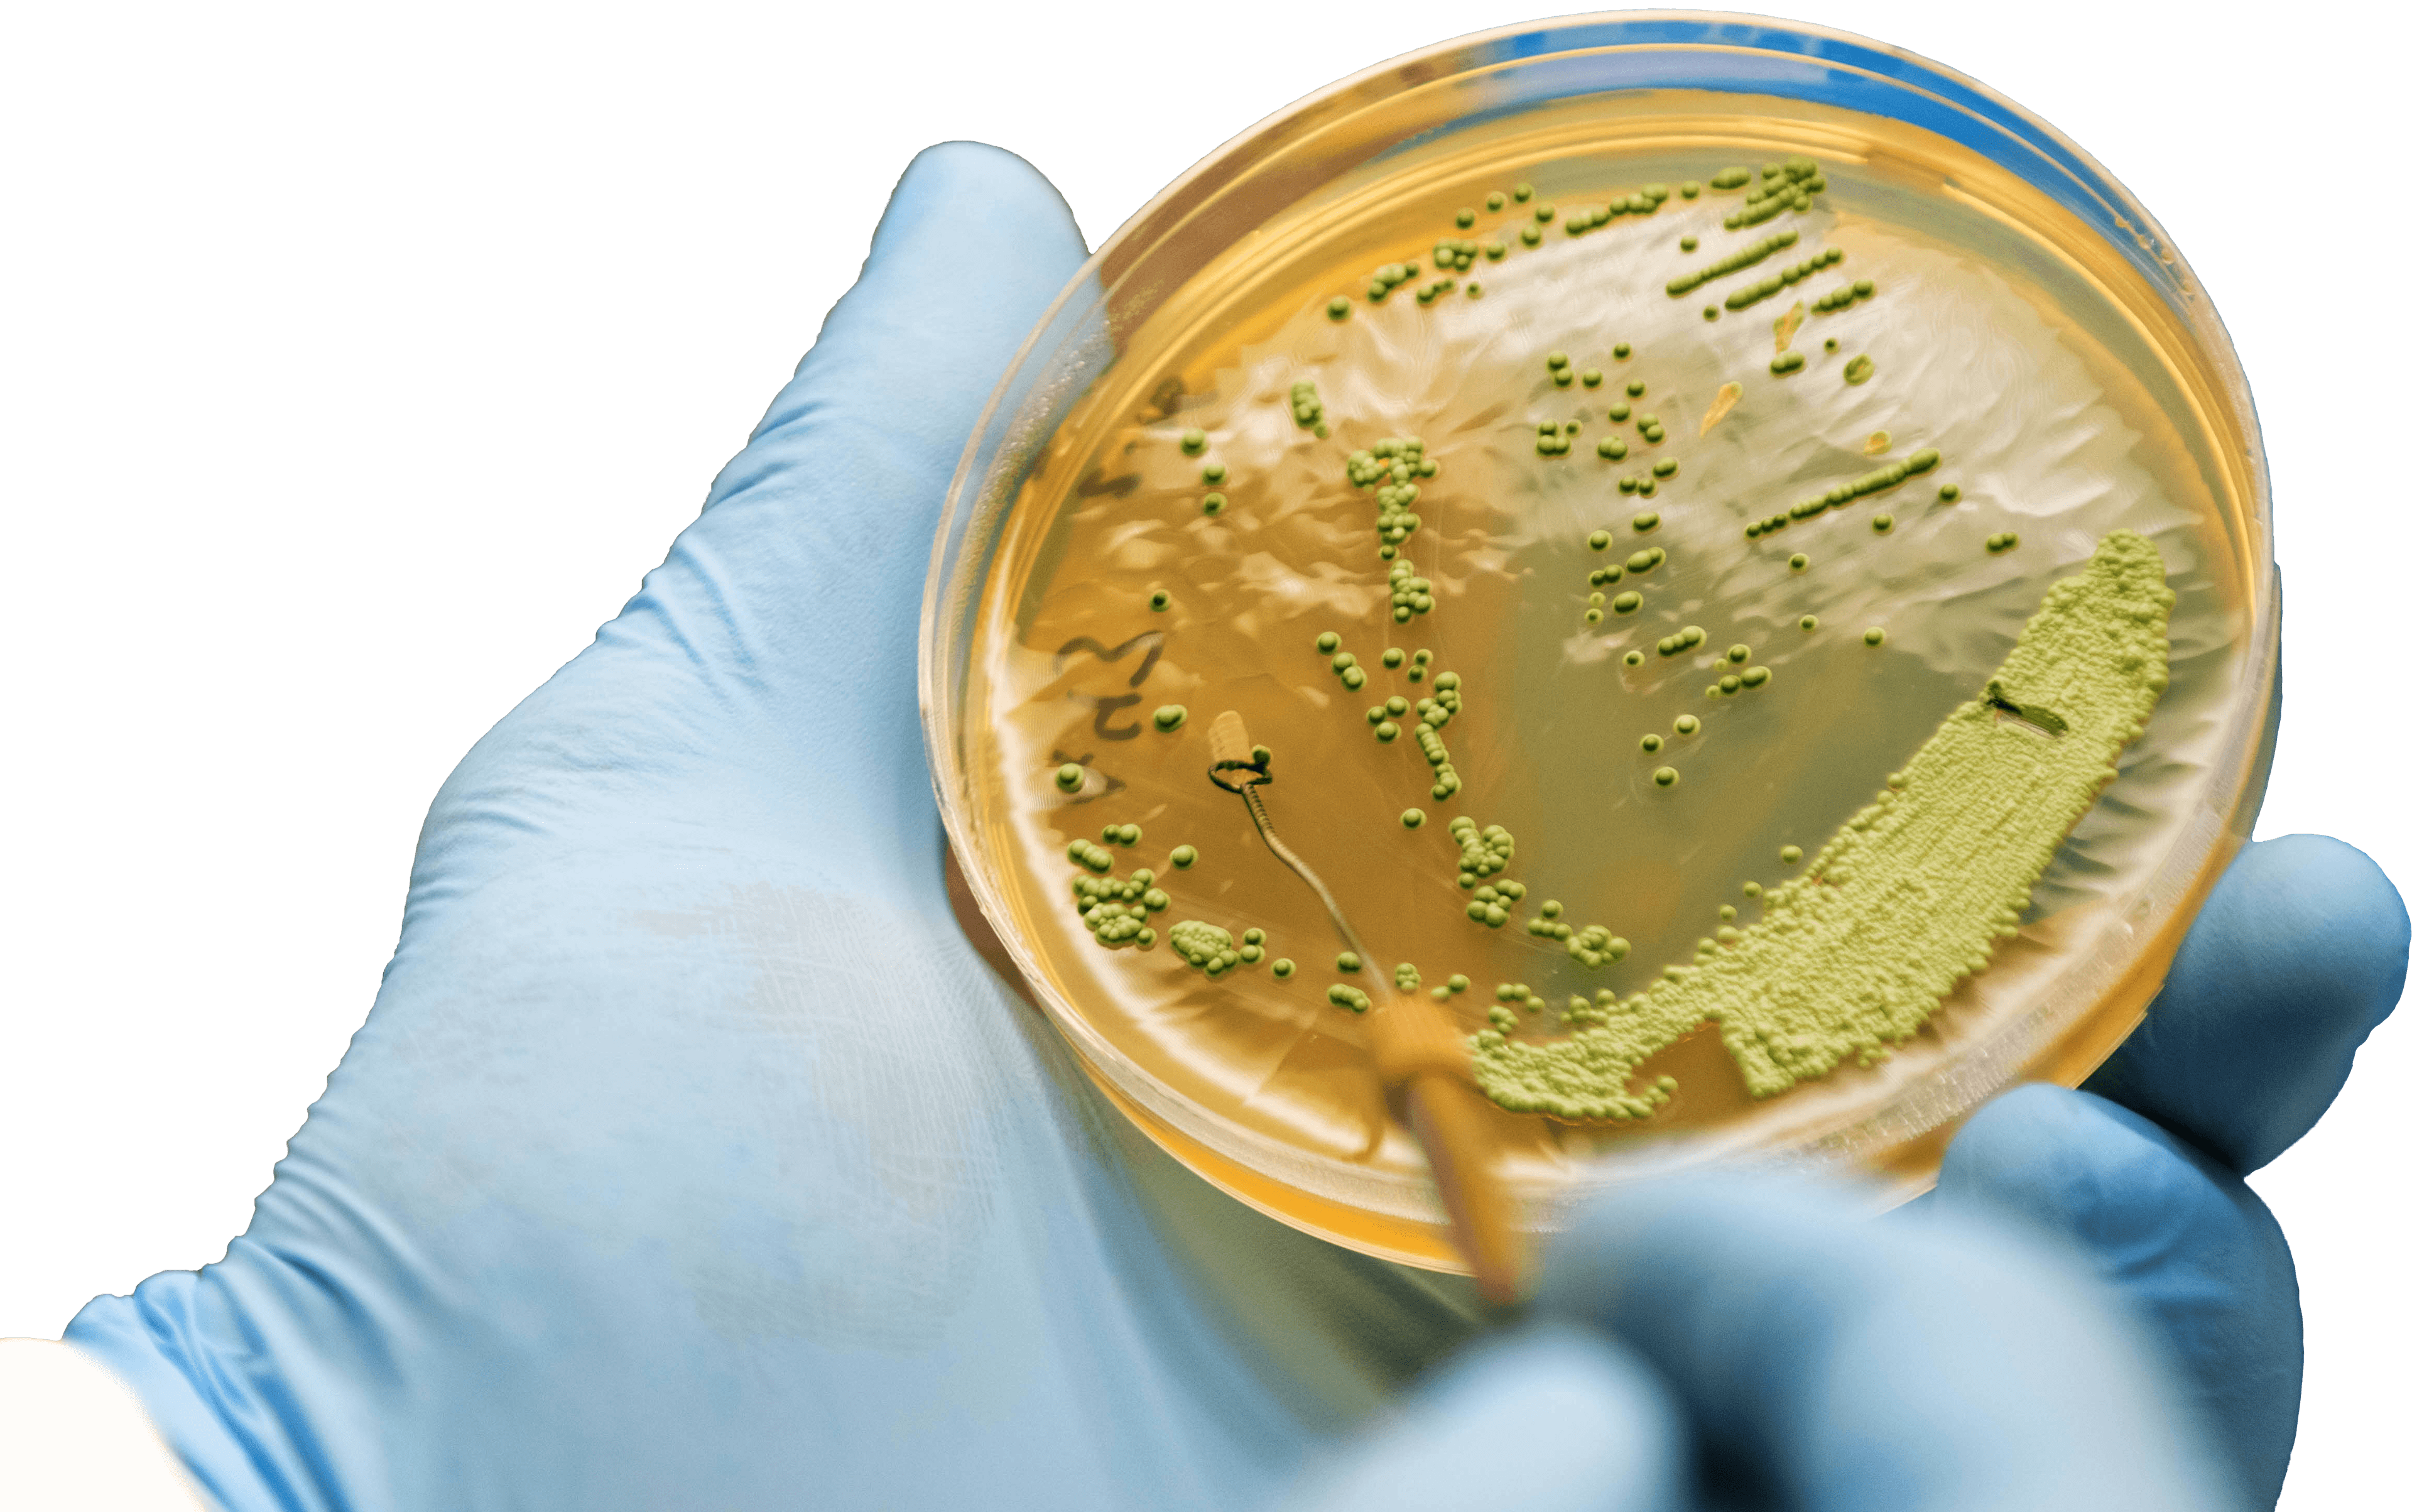
Photo from an Imperial Yeast production facility.

Strain Banking
Differentiate your beer. Partner with Imperial and bank your unique strain today!
Learn More.jpg&w=3840&q=75)
Toll Manufacturing
Ask us about custom fermentation and manufacturing solutions for many industries including food, beverage, and ethanol.
Learn More